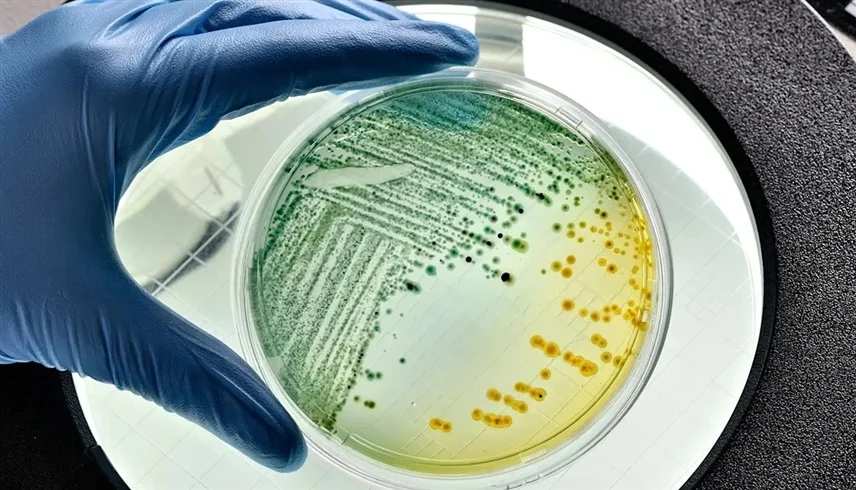

تجارب فضائية تكشف طريقة جديدة لمحاربة البكتريا المقاومة للأدوية
تتطور الفيروسات بشكل مختلف في الفضاء، فتصبح أكثر فاعلية ضد البكتريا المقاومة للعلاج، ولكن أبحاثاً جديدة، أُجري جزء منها على متن محطة الفضاء الدولية، تشير إلى أن “انعدام الجاذبية” قد يساعد العلماء في مكافحة البكتريا الخارقة المقاومة للأدوية.
وبحسب “فوكس نيوز”، تعرّف وكالة ناسا انعدام الجاذبية بأنها الحالة التي يبدو فيها الأشخاص أو الأشياء بلا وزن، وقد أظهرت تجارب أجراها باحثون في جامعة ويسكونسن-ماديسون أن الفيروسات والبكتريا تتصرف بشكل مختلف في ظروف شبه انعدام الوزن.
ففي الفضاء، تطوّر هذه الفيروسات والبكتريا تغيرات جينية لا تُرى عادة على الأرض.
سباق تسلح بين البكتريا والفيروسات
وفي تجاربهم، ركز الباحثون على الصراع والتفاعلات بين الفيروسات التي تصيب البكتريا وميضفيها مثل بكتريا الإشريكية القولونية، حيث يوصف هذا الصراع بأنه سباق تسلح تطوري، يدفع كل طرف للتكيف باستمرار للتفوق على الآخر.
وبينما دُرست هذه التفاعلات بين البكتريا والبلعميات جيداً على الأرض، إلا أن الدراسات التي تناولتها في الفضاء، حيث يمكن أن تؤدي إلى نتائج مختلفة، قليلة.
وفي هذه الدراسة، قارن الدكتور فيل هوس وزملاؤه مجموعتين من عينات بكتريا الإشريكية القولونية المصابة ببلعمية تُعرف باسم “تي 7”. تمت حضانة مجموعتين من الفيروسات على الأرض، بينما تمت زراعة المجموعة الأخرى على متن محطة الفضاء الدولية.
وقال هوس: “من خلال دراسة هذه التكيفات التي نشأت في الفضاء، توصلنا إلى رؤى بيولوجية جديدة مكّنتنا من هندسة جراثيم ذات فاعلية فائقة ضد مسببات الأمراض المقاومة للأدوية على الأرض”.
وأضاف هوس “هذه النتائج قد تساعد في معالجة العدوى المقاومة للمضادات الحيوية، بما في ذلك التهابات المسالك البولية، التي تزايدت في السنوات الأخيرة”.




